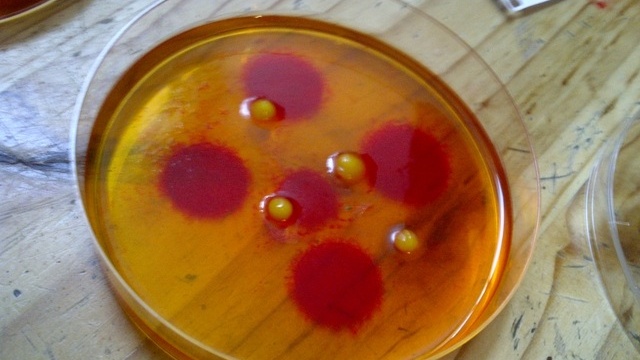

How To Make Your Own Petri Dish Jellos
It's Aliiiiiiiiiiiive!

Ever wondered how to make jello that looks exactly like bacterial cultures? No? Why not? They’re awesome! The folks over at Science Punk threw a super-nerdy science party a while back, and they’ve been generous enough to share with the world their secrets for making petri dish-styled jello yumminess.
And all it takes is:
- Petri dishes
- Jello
- Rice pudding
- Angel delight
- Lab notebook
- Protective clothing
- Rum (optional)
- Jelly sweets
- Food coloring
- Icing for decorating cookies
- Any of the following: brown sugar, cocoa, maple syrup, cake decorations, chocolate drops
The recipe’s pretty simple: just experiment with the above ingredients, adding little jellies as “chromosomes” for texture, as well as food coloring as your artistic eye desires. Pro tip: Don’t start using the food coloring until the jello is half-set, as that’s the stage when it starts to sink to the bottom in globs, giving it more of a science-y appearance.
Full instructions and lots more pictures over at Science Punk. Go forth and create your own edible awesomeness!*
*Not to be confused with Oedipal awesomeness. Don’t create any of that.
(i09 via Science Punk)
Have a tip we should know? [email protected]